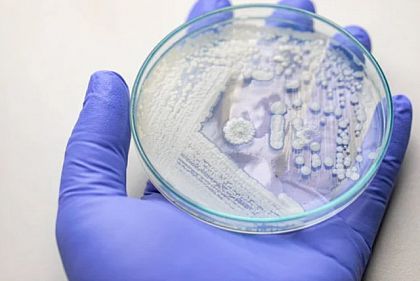
Через неделю на Днепропетровщине возросла заболеваемость кишечными инфекциями

Все новости автора Анастасия Бергарт

Жителям Кривого Рога, чьи квартиры были разрушены из-за ракетного удара 16 декабря, выплатили средства
Криворожанам, чьи квартиры были разрушены в результате ракетного удара 16 декабря 2022 выплатили средства.Об этом в ответ на информационный запрос Первого Криворожского сообщила заместитель директора...

На реке Днепр в створе поста «Херсон» уровень воды вошел в естественное русло
По состоянию на утро 27 июня на реке Днепр в створе поста «Херсон» уровень воды вошел в естественное русло, колебания уровня соответствуют естественным колебаниям этого времени года.Об этом говорится...

Угроза теракта на ЗАЭС: в Днепропетровской области разработан план эвакуации людей
На фоне возможного теракта на Запорожской атомной электростанции в Днепропетровской области будут проводить учения на случай чрезвычайной ситуации, а также уже разработан план эвакуации людей.Об этом...

В результате вражеского обстрела Никополя погибли 2 человека — начато расследование
Вчера, 26 июня, русские военные обстреляли из артиллерии Никополь. Прокуратура начала расследование по факту нарушения законов и обычаев войны, соединенных с умышленным убийством.Об этом идет речь на...

Криворожского нацгвардейца на псевдо «Ведик» наградили медалью «Защитнику Отчизны»
Указом Президента Украины награжден медалью «Защитнику отечества» криворожский гвардеец на псевдо «Ведик».Об этом говорится на странице 21-й отдельной бригады охраны общественного порядка имени Петра...
Через неделю на Днепропетровщине возросла заболеваемость кишечными инфекциями
С 16 по 22 июня в Днепропетровской области заболеваемость острыми кишечными инфекциями (ОКИ) выросла на 32%.Об этом сообщает Днепропетровский областной центр контроля и профилактики болезней.За...

Криворожские спортсмены на чемпионате города по плаванию добыли призовые места
С 23 по 24 июня 2023 года в бассейне ДЮСШ №1 проходил чемпионат города Кривого Рога по плаванию среди молодежи и взрослых.Об этом сообщает Детско-юношеская спортивная школа №2 Ингулецкого района в...

На Днепропетровщине обнаружили троих мужчин, срубивших деревьев более чем на 20 тысяч гривен
В Днепропетровской области разоблачили троих мужчин за незаконную вырубку леса.Об этом говорится на странице «Восточный лесной офис».Отмечается, что в Вольнянском лесничестве филиала «Новомосковский...

Украинская авиация и артиллерия продолжают уничтожать врага
Авиация сил обороны за прошедшие сутки нанесла 6 ударов по районам сосредоточения личного состава противника.Об этом сообщает Генштаб ВСУ.Подразделения ракетных войск и артиллерии за прошедшие сутки...

Сколько криворожан, пострадавших в результате ракетного удара по Кривому Рогу, получили помощь
553 жителя Кривого Рога, чьи квартиры пострадали от ракетного удара российских оккупантов 13 июня, уже получили материальную помощь за счет городского бюджета.Об этом сообщает управление прессы и...

С начала года на Днепропетровщине около 50 тысяч человек получили социальные услуги
В этом году в Днепропетровской области около 50 тысяч жителей получили социальные услуги.Об этом сообщают в Днепропетровской областной государственной администрации.«В Днепропетровской области органы...

Ракетный удар по Кривому Рогу 13 июня: сколько учебных заведений повреждено
В результате ракетного удара по Кривому Рогу повреждения получили 6 учебных заведений.Об этом в ответ на информационный запрос "Первого Криворожского" сообщила заместитель директора департамента...

Услуги Центра Виза криворожане теперь могут получать онлайн
В Кривом Роге теперь можно без посещения ЦНАП получить или заказать административные и другие публичные услуги.Об этом говорится на сайте Криворожского городского совета.Отмечается, на вебпортале...

Погода на последнюю неделю июня в Кривом Роге
Последняя неделя июня в Кривом Роге будет дождливой и облачной, передают синоптики.По данным Укргидрометцентра, весь день будет сохраняться кратковременный дождь. Днем температура воздуха будет...

В течение недели в Кривом Роге зарегистрировались еще 164 переселенца
С начала прошлой недели в Кривом Роге официально зарегистрировали 164 переселенца.Об этом сообщает управление прессы и внутренней политики исполкома Криворожского горсовета.С начала полномасштабного...
